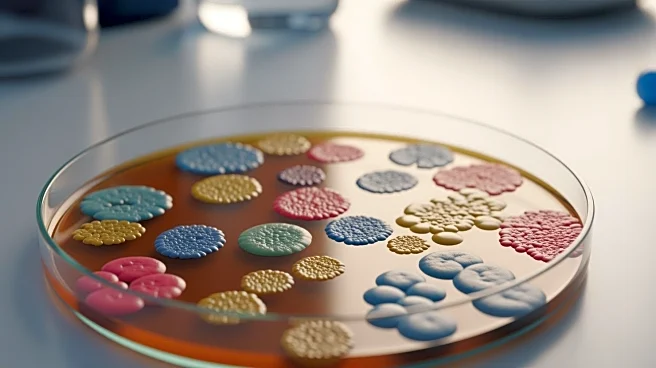
Study Reveals Human Microbiota's Role in Modulating Peanut Allergy Severity

What's Happening?
A recent study by parasitologists from the Biology Center of the Czech Academy of Sciences, published in Nature Communications, has highlighted the importance of dietary fiber in maintaining a healthy gut microbiome and reducing inflammation. The research
focused on the rat tapeworm Hymenolepis diminuta, which thrives in a fiber-rich diet, promoting an anti-inflammatory response in the host. Conversely, a low-fiber diet causes the tapeworm to enter a hibernation-like state, losing its protective effects. The study underscores the role of diet in shaping the gut ecosystem, with fiber-rich diets fostering beneficial bacteria and reducing dysbiosis. This research aligns with health recommendations for adults to consume 25 to 30 grams of fiber daily, though actual intake in Western countries often falls short.
Why It's Important?
The findings of this study are significant as they provide insights into the relationship between diet, gut health, and inflammation. With the rise of autoimmune and inflammatory bowel diseases in industrialized nations, understanding how dietary choices impact gut microbiota and inflammation is crucial. The study suggests that increasing dietary fiber intake could enhance gut health and potentially reduce the risk of related diseases. This has implications for public health policies and dietary guidelines, emphasizing the need for higher fiber consumption to support a healthy gut microbiome and immune system.
What's Next?
Future research may explore the specific types of dietary fiber that are most effective in promoting gut health and reducing inflammation. Additionally, there could be further investigations into how these findings can be translated into practical dietary recommendations and interventions. Health organizations might consider revising dietary guidelines to emphasize the importance of fiber, potentially leading to public health campaigns aimed at increasing fiber intake among populations with low consumption levels.
Beyond the Headlines
The study also raises questions about the broader implications of modern dietary habits on health. As traditional diets with high fiber content are replaced by Western-style diets, there may be long-term consequences for gut health and disease prevalence. This research could spark discussions on the cultural and economic factors influencing dietary choices and the need for systemic changes to promote healthier eating habits.